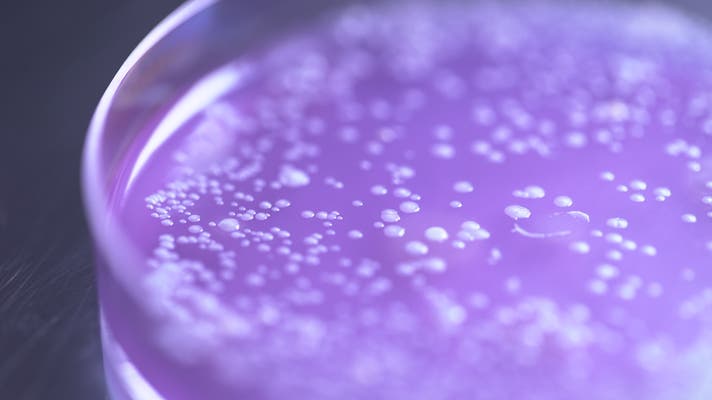

プロジェクト実行者
ストーリー
- あなたの美肌菌を培養した世界に一つのあなただけの美肌菌培養原液※
- 【敏感肌用】防腐剤・界面活性剤不使用優しさを追求。さらに肌状態がわかる「肌チェックシート」付き
- 【マイクロバイオーム】生きた美肌菌培養原液※をクール便で!新しいスキンケア体験
※「美肌菌培養原液」
成分:水、スタフィロコッカスエピデルミディス、グリセリン、グルコース、酵母エキス、α-グルカンオリゴサッカリド
配合目的:保湿・肌のうるおいを保つ・安定化


肌がゆらぐ日。
何を塗ってもピリついたり、乾燥したり。
敏感になった肌に、そっと寄り添うものが欲しい。
ST.エピは、そんなあなたの肌に“わたしだけの答え”を届けるスキンケアです。
まさに、あなたの肌から、あなたの肌のためにつくられたスキンケア。
化粧品に含まれている成分「スタフィロコッカスエピデルミディス」の
原料がサポーター様から採取した菌を元に培養されます。
防腐剤・界面活性剤不使用で、肌へのやさしさを追求。
生きた美肌菌※を、そのままクール便でお届けします。
肌に余計な負担をかけず、肌本来の力を信じて育てていく。
それがST.エピの目指す、新しいスキンケアのかたちです。
※「美肌菌」
スタフィロコッカスエピデルミディス
肌のうるおいを保つ

私たちの肌には、数百種類以上の常在菌がすんでいます。
その中でも美肌菌※は、うるおいを守る“天然の保湿成分”を生み出す、肌にとって大切なパートナーです。
※「美肌菌」
スタフィロコッカスエピデルミディス
保湿・肌のうるおいを保つ




肌は自らうるおいをつくり、守る力を持っています。
その力の源が美肌菌※。
皮脂や汗を栄養にして、天然の保湿成分を生み出してくれる存在です。
※「美肌菌」
スタフィロコッカスエピデルミディス
保湿・肌のうるおいを保つ
肌が本来もつうるおいバランスに着目し、健やかな肌環境を保つことを目指した処方です。
肌は一般的に弱酸性の状態が安定しているとされています。日々のスキンケアによって、うるおいを保ちやすい肌環境を整えることが大切です。

プロジェクトにご参加いただいた方には、
**肌菌バランスをチェックする“肌チェックシート”**を特典としてご提供。
あなたの肌の皮膚常在菌から美肌菌※を選定し、スキンケアアドバイスシートを作成します。自分の肌を知ることが、肌悩み解決の第一歩。
※「美肌菌」
スタフィロコッカスエピデルミディス
保湿・肌のうるおいを保つ

2個セットご購入の方には更に、美肌菌※を洗い流し過ぎない石鹸も!
※「美肌菌」
スタフィロコッカスエピデルミディス
保湿・肌のうるおいを保つ

肌菌を守るには、洗いすぎない洗顔が大切。
2個セットご購入の方には更に特典として
「エルピダワドゥン30g 」販売価格:1,650円(税込)もお送りします。
<成分/配合目的>
カリ含有石ケン素地(洗浄成分)、DPG(保湿・溶剤)、水(溶剤)、グリセリン(保湿剤)、スクロース(保湿・柔軟剤)、ソルビトール(保湿剤)、ステアロイルグルタミン酸2Na(保湿・柔軟剤)、スクワラン(エモリエント剤)、エチドロン酸4Na(キレート剤)、グリチルリチン酸2K(肌荒れを防ぐ)、銅クロロフィリンNa(色素)



朝と夜の洗顔後、清潔な手のひらに3〜4滴をとり、
お顔全体にやさしくなじませてください。
肌が本来もつ力を引き出すために、毎日の習慣としてご使用いただくのがおすすめです。
<保管方法>
※ご使用後は、必ず冷蔵庫で保管してください。
生きた美肌菌※の品質を保つため、常温での保管は避けてください。
※「美肌菌」
スタフィロコッカスエピデルミディス
保湿・肌のうるおいを保つ
仕様・成分について
ST.エピ 美肌菌培養原液は、必要なものだけを厳選し、
お肌にやさしいシンプルな処方でお届けします。
<全成分/配合目的>
水(基材)、スタフィロコッカスエピデルミジス(保湿・抗老化)、グリセリン(保湿・安定化)、グルコース(保湿・安定化)、酵母エキス(保湿)、α-グルカンオリゴサッカリド(保湿)
<フリー処方>
無香料/無着色/パラベンフリー/防腐剤不使用/界面活性剤不使用
内容量: 20mL(約1ヶ月分)
容器仕様: 美容液はガラス容器に充填され、遮光性のあるアルミパウチに個包装しています。
生産国: 日本製
販売予定価格: 7,700円(税込)
<香り>
St.エピは、美肌菌※を“生きたまま”をお届けするため、発酵由来の香りがします。
防腐剤や香料を一切使用していない、菌が生きている証としてご理解いただければ幸いです。
※「美肌菌」
スタフィロコッカスエピデルミディス
保湿・肌のうるおいを保つ

2025年8月下旬:Makuake終了
2025年9月上旬:採取キット発送
2025年9月中旬:採取ガーゼ返送後、商品製造開始
2025年9月下旬:商品完成
2025年9月下旬:商品発送予定




※掲載商品はイメージのためデザインや色、商品名等が変更となる可能性がありますので予めご了承下さい

新商品開発の為に使用します。


私たちが目指しているのは、一人ひとりの肌に本当に合うスキンケア。
そのときどきの肌状態に合わせて、柔軟に寄り添える新しいアプローチです。
皮膚科学に基づく研究を重ねた結果、角層表面の皮脂膜に含まれる成分構成に着目し、類似の組成を持つ保湿成分を、自分自身の肌から採取した美肌菌※を培養することで再現することに成功しました。
それが、私たちが開発した**「美肌菌培養原液」**※です。
※「美肌菌」
スタフィロコッカスエピデルミディス
保湿・肌のうるおいを保つ
※「美肌菌培養原液」
水、スタフィロコッカスエピデルミディス、グリセリン、グルコース、酵母エキス、α-グルカンオリゴサッカリド
保湿・肌のうるおいを保つ※・安定化。
肌悩みに、“菌”からアプローチ
今でこそ一般的になってきた“美肌菌”※という言葉ですが、私たちがこの研究に着手した20年前には、誰もが「それって何?」という反応ばかりでした。
そこから研究を重ね、皮膚に存在する常在菌の中でも**美肌をサポートする力をもつ※「スタフィロコッカス・エピデルミジス」**に着目し、
その菌を増やすための独自技術を確立しました。
※皮膚を健やかに保つ成分
※「美肌菌」
スタフィロコッカスエピデルミディス
保湿・肌のうるおいを保つ
あなたの「美肌菌」※、未来の肌の味方に
さらに、この美肌菌を生きたまま培養・保管できる特殊技術も開発。
美肌菌※を採取・保存しておけば、肌の状態が変化していくなかでも、過去に採取した自身由来の菌を活用することで、スキンケアへのアプローチが多様になります。
肌の状態には個人差があり、もともとの菌の種類や汗・皮脂の量など、さまざまな要因が影響すると考えられています。
美肌菌※“だけ”では足りない?
だからこそ「菌が作る皮脂膜」ごと届けたい
私たちは考えました。“美肌菌※を育てる”だけでなく、菌が関わる肌表面のうるおい環境に注目し、皮脂膜の構造にヒントを得た成分設計を行いました。
モニターテストでも、使い心地や肌との相性などに関して前向きな声を多くいただいています。
こうして誕生したのが、
**あなた自身の肌から採取し、培養した「美肌菌培養原液」**※なのです。
※「美肌菌」
スタフィロコッカスエピデルミディス
保湿・肌のうるおいを保つ
※「美肌菌培養原液」
水、スタフィロコッカスエピデルミディス、グリセリン、グルコース、酵母エキス、α-グルカンオリゴサッカリド
保湿・肌のうるおいを保つ・安定化
肌を知り、素肌美を追い求めた先にたどり着いた答え
「やっぱり違う」と、肌が応えてくれる。
その実感を、多くの方に届けたい。
美肌菌培養原液※は、肌の声に耳を傾け、完成したのが
“素肌美”を目指すすべての方のためのスキンケアです。
まだまだ可能性を秘めた“肌菌ケア”という分野で、私たちはこれからもパイオニアとして挑戦を続けていきます。
※「美肌菌培養原液」
水、スタフィロコッカスエピデルミディス、グリセリン、グルコース、酵母エキス、α-グルカンオリゴサッカリド
保湿・肌のうるおいを保つ※・安定化
エルピダ製造責任者
藤元正昭
リスク&チャレンジ
私たちは『美肌菌培養原液』の製造に向けて、関係各社と連携しながら、誠意をもってプロジェクトを進めております。 開発過程においては、より良い品質を追求する中で、デザインや仕様が一部変更となる可能性がございます。 また、製造スケジュールにつきましては、プロジェクトの成功を前提として調整を行っておりますが、ご支援の数が想定を大きく上回った場合、原料の調達や製造工程の都合により、お届けが遅れる場合がございます。 その際は、活動レポートを通じて、できる限り早くご状況を共有させていただきます。 なお、お届けする商品がお肌に合わないと感じられた場合には、すぐにご使用を中止いただきますようお願いいたします。 【キャンセルポリシー】 記載させていただいているスケジュールは、あくまでプロジェクト公開時点での予定となります。 応援購入という仕組みの特性上、やむを得ず配送が遅れる可能性がございます。原則として、配送の遅延による応援購入のキャンセルはお受けできませんが、採取キットの配送がリターン予定月から2か月以上遅れた場合に限り、ご希望の方にはキャンセル対応をさせていただきます。 なお、商品自体は採取ガーゼをご返送いただかない限り製造を開始できません。そのため、キャンセルの対象となる遅延は、あくまでも「採取キットの配送」に限られる点をご理解ください。 最後に、『美肌菌培養原液』が、あなたの肌の健やかさと美しさに貢献できることを心より願い、スタッフ一同、真心を込めて製造・お届けしてまいります。 どうぞ温かいご支援をよろしくお願いいたします。
サポーターからの応援コメント
文章のトップに戻る
応援購入する
このプロジェクトはAll in型です。目標金額の達成に関わらず、プロジェクト終了日の2025年09月03日までに支払いを完了した時点で購入が成立します。
決済時に安心システム利用料として2.2%(税抜)がかかります。
インボイス(適格請求書):対応可
【超早割・36%OFF】美肌菌培養原液St.エピ 1本
4,900円(税込)
【超早割・36%OFF:数量 100セット 限定】
一般発売予定価格:7,700円(税込)
・完成商品(美肌菌培養原液 20mL)1 本
・美肌菌採取キット
・肌チェックシート 1 セット
お客様より採取キットをご返送いただいてから、通常約2週間ほどで商品を発送いたします。
本商品はクール宅急便となり、
大変恐縮ですが以下の地域へのお届けができかねます。ご了承ください。
伊豆諸島:青ヶ島村(青ヶ島)・利島村(利島)・御蔵島村(御蔵島)・式根島
小笠原諸島:小笠原村(父島・母島・硫黄島・南鳥島など)
【早割・26%OFF】美肌菌培養原液St.エピ 1本
5,700円(税込)
【早割・26%OFF:数量 100セット 限定】
一般発売予定価格:7,700円(税込)
・完成商品(美肌菌培養原液 20mL)1 本
・美肌菌採取キット
・肌チェックシート 1 セット
お客様より採取キットをご返送いただいてから、通常約2週間ほどで商品を発送いたします。
本商品はクール宅急便となり、
大変恐縮ですが以下の地域へのお届けができかねます。ご了承ください。
伊豆諸島:青ヶ島村(青ヶ島)・利島村(利島)・御蔵島村(御蔵島)・式根島
小笠原諸島:小笠原村(父島・母島・硫黄島・南鳥島など)
【Makuake割・20%OFF】美肌菌培養原液St.エピ 1本
6,160円(税込)
【Makuake割・20%OFF:数量 100セット 限定】
一般発売予定価格:7,700円(税込)
・完成商品(美肌菌培養原液 20mL)1 本
・美肌菌採取キット
・肌チェックシート 1 セット
お客様より採取キットをご返送いただいてから、通常約2週間ほどで商品を発送いたします。
本商品はクール宅急便となり、
大変恐縮ですが以下の地域へのお届けができかねます。ご了承ください。
伊豆諸島:青ヶ島村(青ヶ島)・利島村(利島)・御蔵島村(御蔵島)・式根島
小笠原諸島:小笠原村(父島・母島・硫黄島・南鳥島など)
【超早割・45%OFF】美肌菌培養原液St.エピ 2本
8,470円(税込)
【超早割・45%OFF:数量 50セット 限定】
一般発売予定価格:15,400円(税込)
・完成商品(美肌菌培養原液 20mL)2 本
・美肌菌採取キット
・高級石鹸(30g)1 個
・肌チェックシート 1 セット
お客様より採取キットをご返送いただいてから、通常約2週間ほどで商品を発送いたします。
本商品はクール宅急便となり、
大変恐縮ですが以下の地域へのお届けができかねます。ご了承ください。
伊豆諸島:青ヶ島村(青ヶ島)・利島村(利島)・御蔵島村(御蔵島)・式根島
小笠原諸島:小笠原村(父島・母島・硫黄島・南鳥島など)
【早割・35%OFF】美肌菌培養原液St.エピ 2本
10,010円(税込)
【早割・36%OFF:数量 50セット 限定】
一般発売予定価格:15,400円(税込)
・完成商品(美肌菌培養原液 20mL)2 本
・美肌菌採取キット
・高級石鹸(30g)1 個
・肌チェックシート 1 セット
お客様より採取キットをご返送いただいてから、通常約2週間ほどで商品を発送いたします。
本商品はクール宅急便となり、
大変恐縮ですが以下の地域へのお届けができかねます。ご了承ください。
伊豆諸島:青ヶ島村(青ヶ島)・利島村(利島)・御蔵島村(御蔵島)・式根島
小笠原諸島:小笠原村(父島・母島・硫黄島・南鳥島など)
【Makuake割・30%OFF】美肌菌培養原液St.エピ 2本
10,780円(税込)
【Makuake割・30%OFF:数量 50セット 限定】
一般発売予定価格:15,400円(税込)
・完成商品(美肌菌培養原液 20mL)2 本
・美肌菌採取キット
・高級石鹸(30g)1 個
・肌チェックシート 1 セット
お客様より採取キットをご返送いただいてから、通常約2週間ほどで商品を発送いたします。
本商品はクール宅急便となり、
大変恐縮ですが以下の地域へのお届けができかねます。ご了承ください。
伊豆諸島:青ヶ島村(青ヶ島)・利島村(利島)・御蔵島村(御蔵島)・式根島
小笠原諸島:小笠原村(父島・母島・硫黄島・南鳥島など)
「Makuake(マクアケ)」は、実行者の想いを応援購入によって実現するアタラシイものやサービスのプラットフォームです。このページは、 コスメ・ビューティーカテゴリの 「あなたの肌菌が作り出したあなただけの天然保湿成分美容液」プロジェクト詳細ページです。